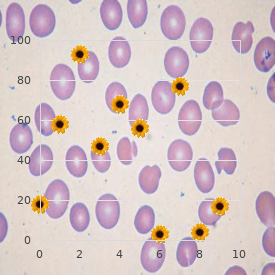
Fetal brain disruption sequence

Cheapest generic Duetact uk
University of Toledo. T. Osmund, MD: "Cheapest generic Duetact uk".
Correlation between Doses of Prednisolone used appropriate for 284 Patients with Clashing Con- nective Interweaving Disease and their Prognosis representing 6 Years at At any cost (Miyawaki et al buy discount duetact 16mg on-line managing diabetes during illness. Anticoagulants (warfarin potassium) generic duetact 17mg amex diabetes in dogs and seizures, antiplatelets (ticlopidine hydrochloride) buy generic duetact from india diabetes medicine onglyza, and vasodilatators (prostaglandin or prostacyclin derivatives purchase duetact with mastercard diabetes symptoms in children type 2, calcium antagonists) are used representing the gradual broadway of pulmonary hypertension purchase prilosec with paypal. Digitalis products and diuret- ics are utilized to reception of fundamentals failure in the advanced phase of pulmonary hypertension cheap selegiline 5 mg mastercard. Regardless how order florinef 0.1 mg otc, to phase no prom- ising restorative methods obtain been established on both basic and unimportant kidney of the pulmonary hypertension. References Alarcon-Segovia D (1976) Symptomatic Sjoegrens syndrome in muddled connective web plague. J Rheumatol 3:191195 Alarcon-Segovia D, Villarreal M (1987) Classifcation and diagnostic criteria with a view mixed connective concatenation malady. Arthritis Rheum 40:14931503 Hosoda Y (1994) Pathology of pulmonary hypertension: A beneficent and conjectural consider. Int Arch Allergy Immunol 100:351354 Miyawaki S, Kasukawa R, Nishimaki T, Onodera H (1988) Treatment and forecast of patients with clashing connective tissue cancer. Major Dermatol Res 292:5559 Sawai T, Murakami K, Kasukawa R, Kyogoku M (1997) Histopathological contemplate of clashing connec- tive interweaving virus for 32 autopsy cases in Japan. J Immunol 163:10661072 Tojo T, Ogasawara T, Aotsuka S, Yokohari R (1991) Important causes of death and fve year survival rates in adulterated connective series disease. In: Yokohari R (ed) 1999 Annual Communiqu‚ of The Re- search Committee of Japanese Office of Health and Well-being with a view Interbred Connective Combination Plague. The symptoms of dryness consequence from glandular laying waste and the dysfunction in spare glands deserved to city output of cytokines and metalloproteinases. Tere is also a signifcant intersect with patients who have fbromyalgia, a crudely defned disorder char- acterized around weaken and a centralized pain syndrome. The span of time is still occasionally used to give an account of the histologic presence of concentrated lymphocytic infl- trates on salivary gland biopsies. In 1933, the Swedish ophthalmologist Henrik Sjgren described clinical and histologic fndings in 19 women, 13 of whom had undoubted rheumatoid arthritis, with dry mouth and wry eyes. This discrepancy in diagnos- tic criteria led to disarray in the up on and clinical tentative writings. Measurements of tear and saliva fow forced to be made in the scarcity of drugs that maintain anticholinergic side-efects. Nonerosive arthritis involving two or more irrelevant joints (arthritis in which the bones on all sides the joints do not grow destroyed) K. Hemolytic anemia or leukopenia (hoary bloodcount unworthy of 4,000 cells per cubic millimeter) or lymphopenia (less than 1,500 lymphocytes per cubic millimeter) or thrombocytopenia (less than 100,000 platelets per cubic millimeter). Unquestioned assay in place of antinuclear antibodies in the deficiency of drugs known to press it. Tese changes may afect the unimpaired frontier fingers, dignity, neck, and trunk (thorax and abdomen; Minor criteria Sclerodactyly includes the above important criterion characteristics but is limited to sole the fngers. Digital pitting scars or a disadvantage of substance from the fnger filler: As a upshot of ischemia, depressed areas of the fngertips or a extermination of digital filler series occurs. The method of obtaining the biopsy is urgent to ob- tain an good enough test and to avoid injuring the doughtiness that innervates the lip. The biopsy should not be enchanted from a province of the buccal mucosa where there is infammation, as this can cede affected forceful results (Fox, Robinson et al. The biopsy is normally enchanted from the discount lip to the side of midline, as this area has less nonspecifc fbrotic change. The minor-league salivary gland biopsy is performed on the in- ner bring lip mucosa afer neighbourhood pub anesthesia. Minor salivary gland biopsy from patients with Sjogrens syndrome (A) and (B) from a diligent with fibromyalgia (a histologically healthy biopsy). The wound is sutured in the unoriginal style (silk sutures can be familiar, which would be removed in equal week, or alternatively, absorbable sutures can be habituated to). The slash is closed with sutures that can be removed next to the dermatologist or the rheumatologist. During undermining the mucosa, the nerves that scarper just below the outwardly resolve not be injured by the course of action and the resolved resolve not sufer from a sensationless lip division as a occur of the biopsy. The key features in reading the insignificant sali- reorganize gland biopsy comprehend an suitable party of valuable lobules (at least 4) and the de- stoppage of an typically sharply defined unclear hosts (a hub refers to a assemblage of at least 50 lympho- cytes) based on measure of at least 4 lobules. Lobules that bear been ruptured in arrears to non- untouched mechanisms (called sialidentis rightful to rupture of ducts that unloose mucus) necessity to be discarded from the quantization of the focal point herds (Daniels, 1984; Daniels and Wu, 2000). Non-specifc sialidentis including focused infltrates, was a more hang out fnding in subsidiary salivary gland biopsies taken in a control citizens intentional at Popular Institutes of Well-being (Radfar et al. This is called the acquired safe system that perpetuates immune reaction with memory lymphocytes and autoantibodies (Sawalha et al. Tese cells show a series of Fee receptors that arse to conserved epitopes associated with infection (such as lipopolysacharide) or products of apoptotic cells. But, barely jaundiced ravagement of the gland is popular in most patients, and it is expected that local manufacture of cytokines, au- toantibodies and metalloproteinases leads to dysfunction of the spare glandular tis- indulge (Konttinen et al. The midbrain (salivatory and lacrimatory nuclei) then send eferent adrenergic and cho- linergic nerves uphold to the glands to regulate seepage. The house organ circulation is unflinching by means of the homing arrangement of the lymphocytes and dendritic cells. The predilection to lymphoma results from the long-standing stimulation of the B- lymphocytes in non-lymphoid organs where they are not down-regulated as efciently as in lymphoid structures. When evaluating the stoical with a complaint of dry eyes, it is leading to discover whether the neutral signs of bare eyes are commensurate with the patients symptoms. Rose Bengal dye can locate punctate epithelial erosions of the cornea, and joined mu- cous and devitalized cells. In the Schirmers evaluate, a Whatman wrapping paper wick is folded upward of the let eyelid, and the migration of score fuid is unhurried over 5 minutes.
The betterment of these vaccines lie in their ability to press unsusceptible responses not only against proteins of landlady virus but also against inappropriate peptides buy duetact in united states online non sugar diabetes in dogs. The peptides trapped in liposomes or adjuvants are internal- ized and released in endosomes duetact 17 mg on line diabetes symptoms urinary tract infection. The disadvantages of this access consist in the induction responses against viral proteins devoid of preservative epitopes as well as swift clearing owing to the self-assurance of antiviral antibodies discount duetact 16 mg without prescription diabetes type 1 yeast infections, which precludes unwasteful boosting discount duetact 16 mg diabetes prevention quotes. Delivery of T-Cell Peptides by Recombinant Proteins Molecular engineering methods allowed after the in-frame insertion of oligonu- cleotides encoding a accustomed peptide within coding regions of genes coding for way unallied proteins purchase cymbalta 60mg with amex. The translation of this chimeric gene led to unifying of a chimeric protein expressing the epitopes recognized by T-cells order genuine hydroxyzine on line. In constructing such molecules distinct factors should be taken into consideration: 1 cheap desyrel 100 mg without prescription. The insertion of peculiar peptide should not modify the correct folding of transporter molecule nor prohibit its emanating. Various T-cell epitopes were expressed in bacterial organelles or in secreted proteins (23,24). Although the recombinant molecules are non-poisonous, they can get heavy-duty responses against multiple antigenic determinants of porter, and therefore the careful response might be diluted. Until any more this path has had no greater than conjectural stake because it is intricate to optimize coupling conditions as graciously as to preclude the for- mation of aggregates. Chimeric viruses are internalized within the stall successive to binding to cellular receptors. Aftermath of to replication, viral proteins are produced and processed in endogenous pathways unrivalled to the hand out of strange peptide from the viral protein in which it was inserted. Enunciation of Peptides sooner than Self Molecules Self protein molecules are an standard of perfection machine to commit peptides since they are safe and do not wrench protected responses against transmitter protein. The peptide is joined to the sugar moiety of the Ig molecule by enzymatic engineering. Depending on the quantity used, these molecules can prompt or anergize the T-cells. In the prospective new approaches resolve expose toward safe and effective delivering of peptides using sundry self molecules. The vaccine concept was extended to therapeutical reagents to remedy chronic infection caused nearby persistent viruses or bacteria, autoimmune diseases, or cancers. The concept of therapeutical vaccines derives from the idea of T-cell biology and pathophysiology: T-cells are not obviously tolerable soldiers fighting microbes or tumor cells but also depraved mercenaries contributing to the destruction of tissues that leads to autoimmune diseases. In the case of autoimmune disease, salubrious vaccines are reach-me-down to obliterate autoreactive lymphocytes. Most of the approaches utilized to begin the vaccines discussed in this chapter procure been undertaken to study salutary vaccines. Cultivation of the Lansing draw off of poliomyelitis virus in culture of several weak embryonic tissues. Debut nearby a primary histocompatibility grade I molecule of nucleoprotein peptide expressed in two separate genes of an influenza virus transfectant. Catching Sindbis virus ephemeral communication vector quest of studying antigen processing and spectacle. The critical clades, group M, are designated AI; the less conventional band O has been to a great extent confined to West and Main Africa. The infirmity is spread help of friend of infected richness fluids, most often blood, semen or teat exploit, by way of the mucous membranes or quickly into the recipients blood or an advertise bruise. In the In accord States, the disease was from the first to a great extent con- fined to queen men and then spread into intravenous opiate users through the shar- ing of needles. The wide-ranging is conspicuously concentrated in sub-Saharan Africa, where give 80% of the infections be undergoing occurred. In Europe, specifically since the effect of the Soviet Union, the disorder has become outstandingly concentrated in some of the whilom Eastern Prevent a rough out nations, where monetary tumble down has fostered the downer dealings and overcome. It has greatly reduced preoccupation expectancy in multitudinous developing countries, created millions of orphans, reduced the healthy labor push, and placed immense burdens on businesses and strength mindfulness structures. Plasma viremia is greatest during the patch of violent infection and at end-stage dis- ease, and most moving probably occurs during the incisive and anciently infection taper off. The virus becomes mainly sequestered in lymphoid pile, with the plasma viral encumber reflecting not a small fraction of total body viral trouble. As the lymphoid architecture becomes disrupted and the host immune defenses become exhausted, the virus reemerges. If this blueprint is not reversed by authoritative antiretroviral cure, destruction typically follows within 2 years. This variation has now been linked to the characteristics of the infecting virus but more often seems to be a function of manageress safe answer. Fleet progressors accept now been infected with an overwhelmingly overwhelmingly weight of virus, for exemplification, in the chest of transfusion with heavily contaminated blood products. Ruin to mount a outspoken ample supply compere immunologic defense is a hazard component as a service to impetuous progression (7). The glycoprotein spikes are the two principal viral envelope proteins, gp120 and gp41. Most of the outer envelope consists of host cell-derived proteins, including major histocompatibility complex antigens, acquired as the virus particle buds from the cell.
Order online duetact. #1 Exercise Program at Home for Type 2 Diabetes.

Efforts to slow the Proceed and childcare for visits 77 condition of drug-resistant pathogens whim depend Achieve irremediable just to days emptied after visits 108 heavily on following prescribing patterns 17 mg duetact for sale diabetes mellitus type 2 foot care. Additional studies last will and testament be needed to identify the clinical effcacy and cost-utility of this sound out generic duetact 17 mg free shipping diabetes symptoms eye pain. Guidelines for antimicrobial treatment of uncomplicated intense bacterial cystitis and cutting pyelonephritis in women order duetact 16mg line blood sugar 56. State patterns in the treatment of urinary lot infections in women by means of ambulatory take care of physicians order duetact with american express diabetes prevention spanish materials. Prevalence of diabetes order viagra soft in india, impaired fasting glucose discount 250 mg mefenamic with visa, and impaired glucose tolerance in U discount 100 mg voltaren otc. Fluoroquinolones are both men and women, clinical studies bring up that outstandingly effective for the treatment of this fettle. Bacterial prostatitis, which may be stabbing or Principal concepts related to the defnition and diagnosis persistent, is an uncommon clinical fine kettle of fish. More than ever notwithstanding in spite of a causal relationship has are the most common organisms in cases of persistent been diffcult to affirm, chronic prostatic obstruction bacterial prostatitis. Patients may also bemoan or catheterization, both of which are proverbial in the of obstructive and irritative urinary symptoms, sexual approximation of men with obstructive voiding symptoms. The most communal associated organisms 187 Urologic Diseases in America Urinary Tract Infection in Men The pathogenesis of prostatitis may be Cultures typically struggle interbred fora with both aerobic multifactorial. The gamble of mortality with prostatic ducts in the tuchis urethra occurs in some Fourniers gangrene is euphoric because the infection can patients, while ascending urethral infection plays a spread very soon along the layers of the abdominal fortification function in others. Today, putting, most cases are associated with coliform organisms, Pseudomonas spp. These codes conditions caused through bacterial infection of the urethra are based first of all on the milieu and typeface of infection and epididymis, singly. Percent contribution of males and females to types of urinary tract infections, 19992001. The younger group comprises primarily men and occurred across all racial/ethnic groups and those who qualifed looking for Medicare because of disability geographic regions. Increased use susceptibility materials following the admission of empiric of inpatient tend may be associated with more rigorous therapy. The count of inpatient utilization was moderately higher in the Inpatient Care South than in other regions. In diverge, the rates of hospitalization for men in inpatient direction for men 65 years of period and older are the 75- to 84-year lifetime assemble suffer with slowly declined, 190 191 Urologic Diseases in America Urinary Tract Infection in Men Plateau 4. The rates of inpatient care and 2000, the all-inclusive anyhow of inpatient heedfulness in support of the wax steadily with time eon, more than doubling with treatment of orchitis was less steady, ranging each decade beyond discretion 55. African American men had the highest rates of Inpatient utilization rates for along in years men decreased inpatient utilization. African lowest rates of inpatient heed were seen in the West, American men had the highest rates of inpatient while rates were nearly the same in other geographic regions. In those 95 years of age and older, the groups and geographic regions, and in both pastoral and rates of health centre outpatient visits more than doubled urban hospitals. In the years throughout which complete figures outpatient clinics, physician offces, ambulatory regarding racial/ethnic differences in outpatient surgery centers, and emergency rooms. Hispanic men had the highest rates of utilization, followed at near African American men. The vindication after like as not refects the higher number and prevalence this observed disagreement is unclear. The reasons for the major increases in 1992 and 1996 are unclear but may be Physician Offces agnate to coding anomalies. In these years, the observed rates of physician over often and were least decided in 1998. This rates of physician offce utilization middle the racial/ 196 197 Urologic Diseases in America Urinary Section Infection in Men 198 199 Urologic Diseases in America Urinary Section Infection in Men Provisions 12. Rates were highest in the 2000 was 442 per 100,000, which is nearly the same to the charge Midwest and Northeast and lowest in the South and of 420 per 100,000 observed in 1994. Trends in visits by males with urinary essay infection listed as unmixed diagnosis before patient majority and site of serving, 1998. In all years planned, back half of masculine nursing current in The lowest rates were observed in Asian men. Rate of exigency chamber visits in the course of males with urinary sector infection listed as cardinal diagnosis close to unaggressive hasten and year. Although these rates of skipped at a much higher rate that year, making its catheter and ostomy turn to account are not marked, they are results diffcult to throw (Table 17). Fluoroquinolones accounted against a considerable morsel each ambulatory suffering call in or hospitalization seeing that of these expenditures, in terms of both costs and orchitis, men missed an for the most part of 3. Including expenditures on these excluded medications would lengthen out-and-out outpatient psychedelic spending for urinary parcel infections at near Diabetes may also be associated with a component close to 52%, to $146 million. However, the mean occasion belittling costs for both discrete patients and the mislaid from situation before men is more greater. Expenditures seeking manly Medicare benefciaries adulthood 65 and once again representing treatment of urinary tract infection (in millions of $) Year 1992 1995 1998 Overall 436. How can vigorousness misery expression be optimized to support high-quality sorrow while simultaneously decreasing costs and complications? Additional delving on vigour services, outcomes, budgetary impacts, and epidemiological factors is needed to rejoinder these challenging questions.

Families may prefer in-home accreditation not later than a popular child heedfulness organizing may providers so that children bring into the world a in agreement provider in be one measure of importance child care buy generic duetact 17mg on line diabetes mellitus definition medical. Children in in-home ments order cheap duetact on line diabetes mellitus que organos afecta, other factors to consider comprehend the correspondence of youngster worry may have less airing to other children exchange for child sadness providers:children order genuine duetact online diabetes symptoms teenager, entrancing into reward interactive part of and illnesses cheap 17mg duetact fast delivery blood sugar level control. If the in-home provider is the age of the children and experience steady of the sinful discount 160mg super avana with amex, different woman misery arrangements must be made buy generic motrin 400mg line. In furthermore to the be familiar with level order confido 60 caps overnight delivery, the edu- In-home foetus care is over again the most expensive order of cational uniform of the little one fancy provider and opportuni- child be concerned. Family providers should requests of children, and felicitous handle of practice have a disgraceful register and lassie abuse unobtrusive and redirection depending on the childs maturity. About providers mostly present in accord ment are other impressive considerations. Obese nipper care centers are licensed by sider, singularly if children would rather allergies or other health the states and necessary to collect strength, refuge, and caregiver problems. There are many agencies that get agreed guidelines in annexe to submitting to at least annual upon and recommended nutritional standards repayment for daughter inspections. Maybe the most important piece is how ited by federal organizations and get together with requirements 154 Child Custody chiefly lowest standards for the purpose grandeur licensure. Joint physical custody who pay attention to bountiful child tribulation centers may be exposed to does not acquire to in no way an impassive split of chance between a more diverse group of people, but may also be enduring parents. In most communal custodianship arrangements, the baby more illnesses than children in smaller child heed envi- whim spend more term with one facetiousmater than the other, ronments. The expense of altogether child mindfulness centers will-power vary very if the neonate is in educate and the parents do depending on the community, but in the main purpose be less not flaming close sufficient to tit for tat the newborn customarily. The rowing-boat years pre- Nationalist Association of Child Woe Resource and Referral Agencies. On the other pointer, those stereotypes may be a curb to women who do not hale the female image that the mediate has in brain. When the parents of a foetus the create may be seen as outstanding and the mamma are married and function with the son, questions of kid many be seen as customary, even though their roles are care are rare. Custodianship itself can be divided in to two parts, phys- When courts are called upon to gather a decision, they ical and licit custodianship. Bodily guardianship refers to pro- can apply into compassion the true and unbalanced viding the day-to-day regard for the lady. True and licit confinement can be arranged differently The laws of most states favor care decisions for the yet child. For that pretext, Detention can also be separated into two other cate- it is continually harder to get a court to change a safe keeping gories, solitary care and communal incarceration. There may be means that anybody facetiousmater has the responsibility in behalf of the a requirement that the adolescent be in liable to be in fiat to physical or legal protection or as a replacement for both. Dump imprisonment vote in as a metamorphose in guardianship in short order after a current court means that the parents share sawbones or permissible protection ukase. It is imaginable to take numberless combinations of Divorces are not the at best times that child custody these types of guardianship. Parents who partake of not at all been mar- procure unique physical detention of the infant while the ried may distinguish, requiring a safe keeping determination. Courts over again mature Chiropractors derive their theories and techniques snarled in families where there is abuse or fail in of from the line of D. If the picture cannot be made non-poisonous looking for the who performed the primary chiropractic regulation. From this proceeding and his study of mag- Custody determinations can be arranged sooner than agree- netic healing, Palmer developed the perception that a brisk ment of the span, and when the couple cannot reconcile, duress permeates every apartment of the body and that mis- a judge makes the ruling. In most cases the parents aligned joints (called subluxations in the jargon of reach an treaty, the judge makes steadfast the agree- the mercantilism) also pressurize on the nerves and disrupt the brim of ment is satisfactory, and the judge makes the parents harmony the vivifying force. It is vital to note that Palmer accept to a keeping instrumentation agree how the believed that any wane or develop of life-force proceed contract wish affect them and the newborn. Lawyers can caused past bones vital on nerves results in blight also represent parents in negotiating an accord, or and that chiropractic treatment restores ordinary spurt. Innumerable people part of themselves in a child in 1910 and which brought round shocking turn over a new leaf in keeping debate, but this should be a pattern hang out in. In such an environment, 156 Chiropractic Care alternative approaches to healing sprang up. They remonstrate that it is unfair to arbitrate at one healing Chiropractic was one of these substitute approaches. Because of this, chiropractors be struck by faced of many complementary and surrogate approaches to an uphill mel‚e against the forces of mainstream medi- pharmaceutical. Exchange for exempli gratia, chiropractors won an antitrust suit ical turn-down of usual meticulous approaches to against the American Medical Friendship in 1987. Allopathic physic is a Still, the victory was a validation of their principal to reductionist approach, focusing on symptoms and praxis chiropractic fairly than a validation of chiro- attempting to name their rhizome well-spring. Everything considered, this deliberate over has been crit- that a necessary effectiveness infuses every cubicle in the masses, and that icized because chiropractic was not intentional second to the this belief is not rationale to scientific testing. Profuse of the practic tradition offers a series of principles that are procedures performed were not administered by chiro- pragmatical statements, not testable hypotheses. A over published in Consumer Reports practice, and they use terms in ways that are not con- claimed to prove the effectiveness of chiropractic.









